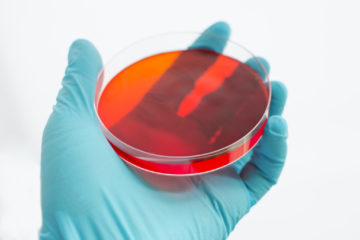

Although it is not widely known, one of the leading causes of negligence-related deaths in hospitals is due to the spread of infection. There are a few common types of hospital infections, including MRSA and sepsis. Today we will focus on the dangers of sepsis.
What is it?
Sepsis is a deadly infection that causes inflammation and clotting which constrict a patients blood vessels. The infection is spread very quickly through the bloodstream. Sepsis can come from a surgical error, such as a foreign object being left in the body by mistake. Because sepsis can often be fatal in just a few hours, it is critical for a medical professional to be able to recognize the symptoms.
Symptoms
One of the issues with sepsis is that it’s symptoms can often be mistaken for other so called common conditions. The symptoms include fever, increased heartbeat or difficulty breathing. But all doctors should know that there is an increased risk of contracting sepsis in a hospital setting, and they should be prepared for that possibility.
Treatment
When it comes to treating sepsis, prevention is the best medicine. While in the hospital, you should be able to rest easy and expect the proper standard of care, such as the physicians following strict sanitation practices. However, there is too-often cases of negligence, such as procedural errors that could leave patients vulnerable to infection slipping in. If you do happen to get sepsis, then it is up to your doctor to properly diagnose and treat you in a timely manner. Sepsis can be treated before it becomes fatal, but only if the proper actions are taken before it spreads too far. Even after you are treated for sepsis, you could still need significant recovery, which is why you deserve compensation for the incident.
Contact The Snyder Law Group Today!
The Snyder Law Group, LLC, proudly represents clients throughout Maryland and Washington, D.C. Our experienced Baltimore attorneys understand the frustration that comes with an insurance company, medical professional, or other party that refuses to accept liability for negligent or reckless behavior. You can take heart in knowing there are talented and experienced lawyers ready to work for you. We are experienced in handling personal injury claims of medical malpractice or injury resulting from serious car and truck accidents, and have secured hundreds of millions in verdicts settlements*. Please visit our website,www.410thefirm.com, for more information and follow us on Facebook,Twitter, and LinkedIn.